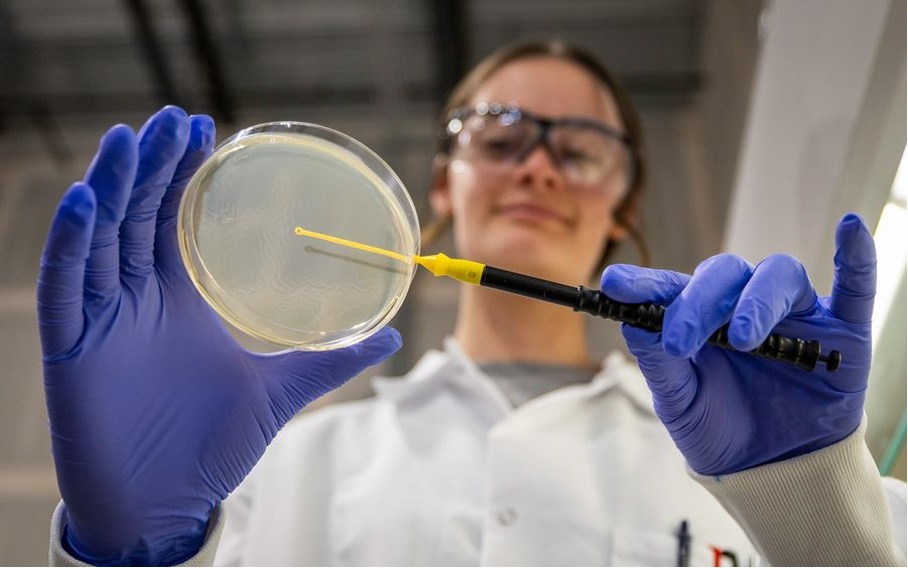

Elektrik altyapısına yönelik artan talep, yeni fikirlere ihtiyaç duyulmasını gerektiriyor.
Liz Dennett / Ekim 2025
Dünya, yapay zekayı adeta Minecraft oynar gibi inşa ediyor; altlarındaki fiziksel sınırlamalara pek aldırmadan veri merkezleri , iletim hatları ve soğutma sistemleri üst üste yığıyor . Herkes modellere ve hesaplamalara odaklanmış durumda, ancak onları çalıştıran donanıma çok az kişi dikkat ediyor.
Modern elektrik altyapısının her parçası –sadece yapay zeka değil– bakıra bağımlıdır. Yapay zeka veri merkezleri ise talebi daha da hızlandırıyor. Bir hiper ölçekli tesis on binlerce ton bakır gerektirebilir. Örneğin, bir Microsoft veri merkezi 2.000 tondan fazla , yani megawatt başına 27 ton bakır kullandı. Bir McKinsey raporu, genel iletim altyapısının yıllık küresel bakır talebini 2031 yılına kadar yaklaşık 37 milyon tona çıkarabileceğini öngörüyor .
Erişilebilir bakır kaynakları tükeniyor . Küresel rezervlerin %70’inden fazlası, geleneksel madenciliğin verimli bir şekilde işlemekte zorlandığı cevherlerde kilitli durumda. On milyarlarca ton bakır, endüstri tarafından göz ardı edilerek, atık yığınlarında ve marjinal yataklarda atıl halde bekliyor; ancak yine de büyük bir potansiyele sahip.
İşte bu potansiyel beni buraya çekti. Jeobilimci olarak başlayıp daha sonra enerji ve bulut altyapısı alanlarında çalışan biri olarak, bakıra olan artan ihtiyacı bizzat gördüm ve bu ihtiyacı karşılamaya yardımcı olacak bilgiye sahip olduğumu fark ettim. 2023 yılında, bu unutulmuş kaynaklardan bakır elde etmek için Endolith adında bir girişim kurdum . Kullanılan araç matkap veya dinamit değil, mikroplar .
Mikrobiyal Madencilik Nasıl Çalışır?
Bu mikroorganizmalar doğal olarak evrimleşmiş, sahada kullanılabilir ve kalkopirit ve enargit gibi karmaşık cevherlerden bakır geri kazanımında son derece etkilidir . Gerçek dünya koşullarında, gerçek müşterilerle çalışarak, liç yığınlarında gelişirler. Ve bonus olarak: Geleneksel yöntemlere göre daha az enerji kullanırlar, daha fazla bakır sağlarlar ve daha küçük bir çevresel ayak izine sahiptirler.
Peki bu geleneksel yöntemler nelerdir? Tipik olarak, madenler cevherlerden bakırı çıkarmak için kayayı öğütür, cevheri yoğunlaştırır ve ardından yüksek sıcaklıkta eritme veya güçlü asitlerle kimyasal liçleme yöntemlerini kullanır. Her iki yaklaşım da enerji yoğundur, bakırı açığa çıkarmada yavaştır ve büyük miktarda atık ve emisyon bırakır.
Buna karşılık, “mikrobiyal yardımcılarımız” biyolojik liçleme adı verilen doğal süreci hızlandırarak çalışır . Eritme veya sert asitlere güvenmek yerine, Endolith’in mikropları cevhere yapışır ve bakırı daha hızlı bir şekilde çıkarır. Farklı kaya türlerinin kimyasına uyum sağlarlar, daha fazla metal geri kazanırlar ve bunu daha düşük enerji kullanımı ve daha az çevresel etkiyle yaparlar.
Bunu mümkün kılmak için makine öğrenimine güveniyoruz. Binlerce mikroorganizmadan elde edilen genomik ve metabolik veriler, kalkopirit veya enargit gibi aşırı cevherlerde hangi suşların hayatta kalabileceğini ve farklı çevresel koşullar altında nasıl performans göstereceklerini tahmin etmek için modelleniyor. Bu modeller, hangi mikrobiyal toplulukların kullanılacağını, her bir saha için nasıl ayarlanacaklarını ve zaman içinde nasıl adapte olacaklarını yönlendiriyor. Aslında, yapay zeka, biyolojiyi deneme yanılma yönteminden bakır geri kazanımı için ölçeklenebilir bir sisteme dönüştürüyor; bakır da yapay zekanın kendi büyümesini besliyor.

Yaklaşımımız, BHP de dahil olmak üzere dünyanın en büyük bakır üreticilerinden bazıları tarafından zaten onaylanmıştır . Mikrobiyal geri kazanım daha temizdir. Ölçeklenebilirdir. Uyarlanabilir. Modüler biyolojik kuluçkahanelerimiz – özel olarak tasarlanmış mikropları yetiştirmek ve sunmak için tasarlanmış saha üniteleri – günler içinde konuşlandırılabilir. Yerel koşullara göre ayarlanabilirler. Daha önce dokunulmamış yataklarda bakır geri kazanımını uygulanabilir hale getirirler. Bu araç, madenciliğin göz ardı ettiği ve teknolojinin nadiren dikkate aldığı tedarik zincirinin bir bölümüne erişim sağlar.
Bakır Krizi Yapay Zekayı Yavaşlatıyor
Yapay zekâ altyapısı hakkındaki konuşmalarda bu katmana nadiren değinilir. Hesaplama maliyetleri ve enerji ihtiyaçları anlatıya hakimdir, oysa bakır tüm sistemin temelini oluşturur.

Yapay zekanın fiziksel yönü çoğu zaman gözden uzaktır. Varlığı, bir veri merkezi projesinin bir transformatörün zamanında teslim edilememesi nedeniyle gecikmesi veya elektrik şirketlerinin yeni bilgi işlem yüklerini destekleyecek kadar hızlı iletim hatları inşa edememesi durumunda belirgin hale gelir. Bunlar, göz önünde saklanan bakır sorunlarıdır.
Son teknoloji bilişim sistemlerini kullanmaktan heyecan duyan ancak kablolamanın bunu kaldırıp kaldıramayacağından sessizce endişelenen saha mühendisleriyle görüşmelerim oldu. Yazılım hazır diye altyapı otomatik olarak gelişmez. Bakır jeoloji ve zamana bağlıdır. Madenler yavaş ilerler, geri dönüşüm çok dar bir alanda gerçekleşir ve talep çok hızlı değişir. Daha akıllı biyolojik geri kazanım, bugün kullanabileceğimiz kaldıraçtır.
Şüpheciler, biyolojik liç yönteminin tarihsel olarak kalkopirit gibi sert cevherlerle mücadelede zorlandığını belirtiyor . Süreçler genellikle yavaş, eksik veya büyük ölçekte yönetilmesi zordu. Mikrobiyal bilim ve yığın mühendisliğindeki son gelişmeler bu açıkları kapatıyor. Yapay zekanın mikroorganizmaların optimizasyonuna rehberlik etmesiyle, artık doğru suşları doğru cevherlerle eşleştirebiliyoruz ve biyolojinin eski yöntemlerin yetersiz kaldığı yerlerde başarılı olabileceğini gösteriyoruz.
Teknoloji çoğu zaman maddi dünyanın hırsla aynı hızda ilerleyeceğini varsayar. Ancak hırs tek başına yerden kaya çıkaramaz ve kesinlikle bakır üretemez. İnanç ile altyapı arasında bir kopukluk görüyorum. Bu geleceğin geleceğine inanıyoruz, ancak onu desteklemek için gereken fiziksel sistemler onlarca yıl geride. Kalıcı bir şey inşa etmek istiyorsak, hırs ve girişim sermayesinden daha fazlasına ihtiyacımız var . Metale ve onu çıkarmak için daha akıllı yollara ihtiyacımız var.
Eğer inşa etmeye devam etmek istiyorsak, neyle inşa ettiğimiz konusunda net olmalıyız. Bu da ekstraksiyon, kablolama ve kimya anlamına gelir; sistemin nadiren manşetlere çıkan ancak ilerlemenin mümkün olup olmadığını belirleyen parçalarıdır.
Yapay zekâ çağı heyecanla değil, bakırla sürdürülecek. Ve toparlanmada bir sonraki sıçrama, minik, kadim ve canlı mikroplardan gelebilir.
Daha fazla makaleye ulaşmak için aşağıdaki linkleri kullanınız.
- Bu Yapay Zeka, Gizli Pil Metalleri Hazinelerini Arıyor ›
- Bakır Geniş Bant, Fiber Optiklere Üstün Geldiğinde ›
